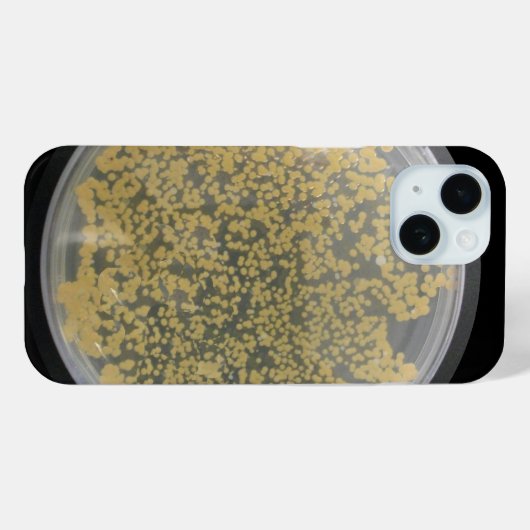
Bord Bacteriecultuur bedekt met kolonies Case-Mate iPhone Case (Achterkant (horizontaal))

€ 40,60
per hoesje
Bord Bacteriecultuur bedekt met kolonies Case-Mate iPhone Case
Bekijk productdetailsOver Casemate Hoesje
Aangeboden door
Over dit ontwerp
Bord Bacteriecultuur bedekt met kolonies Case-Mate iPhone Case
Een petrischaaltje met voedingsagar en veel mooie, schattige bacteriekolonies sieren deze zeer beschaafde telefoonhoes. Kijk maar naar al die kleine steden van micro-organismen. Zijn ze niet schattig? Als je ja zei, dan ben je de persoon voor wie dit hoesje is gemaakt. Je bent een professional en kan een lus pakken en strepen als een meester. Kijk hoe mensen naar je telefoon staren als er een groot vraagteken boven hun hoofd verschijnt. Als ze vragen "Wat is dat in hemelsnaam?" kun je zeggen, "het is gewoon een kleine cultuur." (misschien zeg je dat niet) Afbeelding copyright 2012 door Margaret E. Cmelik.
Ontwerp van international designer
Klant beoordelingen
4.8 van 5 sterren beoordeling5 aantal beoordelingen
5 Reviews
Beoordelingen voor identieke producten
5 van 5 sterren beoordeling
Door M.3 september 2022 • Geverifieerde aankoop
Apple iPhone 17 Pro Max, Tough
Zazzler recensent programma
Stevig hoesje. Mijn zoon is er heel erg blij mee. Mooie print en met de naam van mijn zoon erbij heel persoonlijk: echt zíj́n telefoon
5 van 5 sterren beoordeling
Door Meta G.25 juni 2018 • Geverifieerde aankoop
Apple iPhone 11, Tough
Zazzler recensent programma
Ik had dit hoesje al voor mezelf voor de iPhone SE. Mijn schoonzus vond dit zo leuk dat zij er ook een wilde, maar dan voor de iPhone 5C. Allebei de hoesjes passen perfect om de telefoon. Het ontwerp en de kleuren zijn exact zoals op de site wordt weergegeven. Lekker felle kleuren!
5 van 5 sterren beoordeling
Door R.28 september 2019 • Geverifieerde aankoop
Apple iPhone 11, Barely There
Zazzler recensent programma
Het ontvangen object is zeer mooi. Het is een correcte weergave van de foto op internet
Tags
Andere Info
Product ID: 179340672627167670
Ontworpen op: 7-2-2021 19:57
Rating: G
Recent bekeken items



